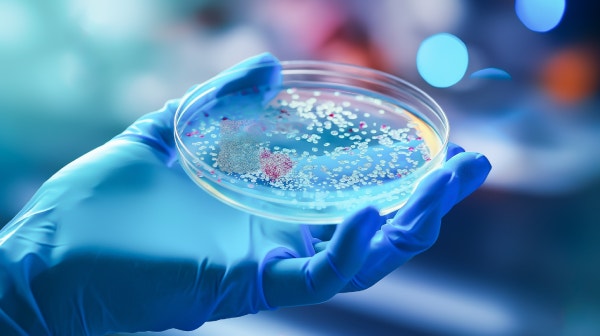

Food and Beverage
Support sterility and traceability in microbial quality testing
The QPix FLEX system helps quality and R&D teams in food and beverage industries automate microbial screening, plating, and traceable colony picking. Its disposable tip option and barcode reader make it well-suited for regulated environments requiring sample integrity and documentation.